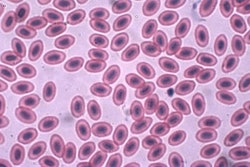
Chicken red blood cells magnified 1000 times | John Alan Elson | Wikimedia Commons

Pet food palatability has always been an intricate science, but with the increasing complexity of consumer needs and pet food formulation, it has become more extensive than ever.
“The pet food market has been experiencing a long-term underlying shift based on the evolution of the relationship between the pet owner and his animal,” said Sophie Munier, communication manager for Diana Pet Food. “An increasing number of pet owners are becoming pet parents. They expect mealtime to be a privileged moment to create emotional bonds with their animal. Being sure that their animal doesn’t simply eat, but enjoys its food is essential to them. When thinking about their products’ palatability, pet food manufacturers should keep in mind that they not only need to satisfy pets’ appetite, they also need this satisfaction to be clearly perceptible by the owner.”
There are several ways the palatability segment of the pet food industry is responding to this pet-owner relationship shift, from contributing to marketing claims that satisfy consumer demand to exploring new technologies and new areas of study that might help shed light on the complexities of pet palatability preferences.
Palatability’s role in the specialization of the pet food market
“What’s not in the bag—non-GMO, grain free, not made in China—these claims are standard, and we expect this list to continue to grow as the regulatory arena gets stricter,” said Debra WIlliams, marketing category manager for AFB International. “Our palatants need to support our customers’ claims and product mandates. In addition, there are niche claims that come from specialized formulations.” Hypo-allergenic pet foods, which must still have matching flavors to their non-specialized counterparts for consistency with the manufacturer’s brand and formulas, are just one example of these needs, said Williams.
Such specialization of claims can also relate directly to palatability, according to Fernando Roberti, technical expert in the animal feed sector for Biorigin. “Over the last few years, among products that have entered the market, a great number have presented claims related to palatability: high palatability, highly palatable, or making reference to specific flavors such as chicken, beef or fish,” said Roberti, referencing data from Innova Market Insights. “With the increasing competition in this industry and a lot of new products being launched in the market annually, new solutions for promoting differentiation are needed.”
Biorigin is addressing that differentiation via yeast, conducting studies on its palatability as both yeast extract and hydrolyzed yeast in dog and cat foods. “Solutions containing yeast extract and hydrolyzed yeast have been shown to have good palatability for both dogs and cats,” said Roberti. “The yeast processing, through autolysis and hydrolysis processes, was an effective tool to improve product palatability, since the processed forms were shown to be more palatable than the inactive one. Hence, processed yeast can be used as a solution for pet food differentiation.”
Still other companies are looking to non-palatants as additional tools. "Some pet food companies are looking to increase the meat inclusion into their kibble formulas as a means to improve palatability, instead of relying on a palatant alone," said Kerry Courchaine, key account manager for Kemin. This plays well into the current high-meat trends becoming more prevalent in the industry. "The use of slurries and frozen blocks as well as alternate techniques to create pet food should become more commonplace if the trend towards higher meat kibble continues," said Courchaine.
Palatability technologies growing to fit the trends
“Engineering and manufacturing must be nimble enough to adapt processing and manufacturing to meet both the R&D demands and the customer demands to provide a high-quality, consistent product,” said Williams. Unsurprisingly, as with other segments of the pet food industry, consumers are playing a significant role in the emergence and expansion of palatability technologies and research. “Pets are more like family every day,” said Williams. “Providing a palatant that is not only tasty but, in combination with the food, provides the pet parent with an observable level of excitement in the pet’s response to the food” is a given for the future success of pet food palatability, she said.
“The evolution of palatability performance definition needs to be supported by an enriched range of measurement methods and criteria taking into account pet owners’ expectations,” said Munier. “These methods should particularly assess the sensorial and emotional dimensions that participate in the pet feeding behavior and in pet food’s performance.”
Among the significant research Diana Pet Food is doing to gain a more comprehensive view of just what palatability entails is a focus on possible genetic influences. “We want to combine knowledge on sensory preferences with genetics—adding one product that will please all cats may not be possible, due to innate or learned tastes,” said Munier. “The idea is to have the genetic profiles of many cats, and then see if we can relate that to the evolution of their taste preferences.”
Genetics is already an accepted key component in human taste perception (see Figure 1); Diana Pet Food’s research goal now is to see if that component extends to cats. Over three years of consumption data from Panelis, its expert center in palatability measurement, Diana Pet Food built a food preference database of 600 cats representing several breeds. It was clear the cats had different preferences toward specific flavors or ingredients. When comparing preferences for fish or meat-based diets, cats were broken down into four classes: 13% were strong meat likers, 27% were light meat likers, 45% were light fish likers and 15% were strong fish likers. Strong preferences were detected in 30% of the cat population studied—but what are the origins of those preferences? According to the research, dietary past is already a clear influencer, while age and sex are not influencers at all. The hypothesis, and current focus, is that genetics may have a role to play, as well.

Genetics has a confirmed influence on human taste preferences. Diana Pet Food hypothesizes that such influences might play a role in pet food palatability preferences, as well.
Beyond research, according to Kemin, new techniques in pet food processing may come into play as palatability needs expand. "Techniques other than traditional hot extrusion, like cold extrusion, allow for higher meat inclusion," said Courchaine. "Cold extrusion processes may allow for the addition of palatants as part of the dry ingredient mix without the capital investment in coating technology."
The overarching direction of pet food palatability
No matter how companies are handling their palatability advancements, one thread runs throughout: The human pet owner must be taken into consideration right alongside the pet actually consuming the product. A well-rounded approach is needed, said the experts, that not only covers all possibilities, but presents results that are apparent to the pet parent.
Read more: Pet food palatability research
Biorigin: Improving pet food palatability: Yeast extract, hydrolyzed yeast
www.petfoodindustry.com/articles/5959
Diana Pet Food: Feline genetic make-up: Understanding cats’ preference drivers